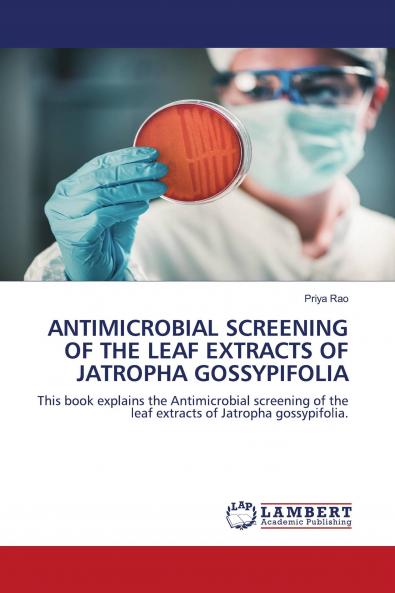
ANTIMICROBIAL SCREENING OF THE LEAF EXTRACTS OF JATROPHA GOSSYPIFOLIA

English
Paperback
₹3363
₹3540
5% OFF
(All inclusive*)
Delivery Options
Please enter pincode to check delivery time.
*COD & Shipping Charges may apply on certain items.
Review final details at checkout.
Looking to place a bulk order? SUBMIT DETAILS
About The Book
Description
Author
Jatropha gossypiifolia Linneus is a Euphorbiaceae plant popularly known worldwide as “bellyache bush” or “black physicnut”. It is a pantropical species originating from South America that is cultivated in tropical countries throughout the world. The present work aims to investigate the antimicrobial efficacy of the extracts of Jatropha gossypifolia leaf collected from Saurashtra region in Gujarat India
Delivery Options
Please enter pincode to check delivery time.
*COD & Shipping Charges may apply on certain items.
Review final details at checkout.
Details
ISBN 13
9786203856316
Publication Date
-06-05-2021
Pages
-84
Weight
-121 grams
Dimensions
-150x220x4.92 mm